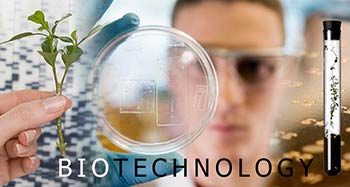
الهندسة الجينية، الاصطفاء الجيني إيديولوجية الأغنياء

ارشيف من :ترجمات ودراسات

اسرائيل تهاجم اوروبا وترددها ضد حزب الله

10 آلاف يتظاهرون ضد مشروع وزير المالية الإسرائيلي

’هآرتس’: ’اسرائيل’ أقامت ممثلية دبلوماسية في احدى دول الخليج

وسائل اعلام العدو: ’اسرائيل’ تسقط طائرة دون طيار تابعة لها قبالة ’نتانيا’

العدوان... كاشف العورات

محاربة الفتنة

من يوقف هذا العبث ؟

الاردن وسوريا وطرد السفير الاسرائيلي

دهشة في الاستخبارات العسكرية الاسرائيلية:الى متى سيصمد الاسد؟

’إسرائيل ديفينس’: محاولة لإحباط صفقة صواريخ ضخمة لسوريا

’جيروزاليم بوست’: الهجوم الاسرائيلي على سوريا أدى الى ترسيخ تحالف الاسد مع إيران وحزب الله

إعلام العدو: عندما يتحدث نصر الله فلنستمع إليه جيداً!

’يديعوت احرونوت’: هل اخطأت ’تل ابيب’ في اعتدائها على سوريا؟

’يديعوت أحرونوت’: واشنطن سرّبت خبر الاعتداء على سوريا وسببت إحراجا لـ’تل أبيب’

رئيس الاستخبارات ’الاسرائيلية’ السابق يحذر ’تل ابيب’ من سكرة النجاحات

لذلك فهموا الدرس

’إسرائيل’ تمهد لخطوات تهويدية جديدة

نتنياهو يبحث هاتفياً مع أوباما الملفّ السوري
الهندسة الجينية، الاصطفاء الجيني إيديولوجية الأغنياء

’اسرائيل’ تخشى تنفيذ عملية ’انتقامية’ ضد دبلوماسييها في جورجيا

شالوم يطالب الحكومة المجرية بدفع الاتحاد الاوروبي لإدراج حزب الله على لائحة الارهاب
 أرشيف موقع العهد الإخباري من 1999-2018
أرشيف موقع العهد الإخباري من 1999-2018